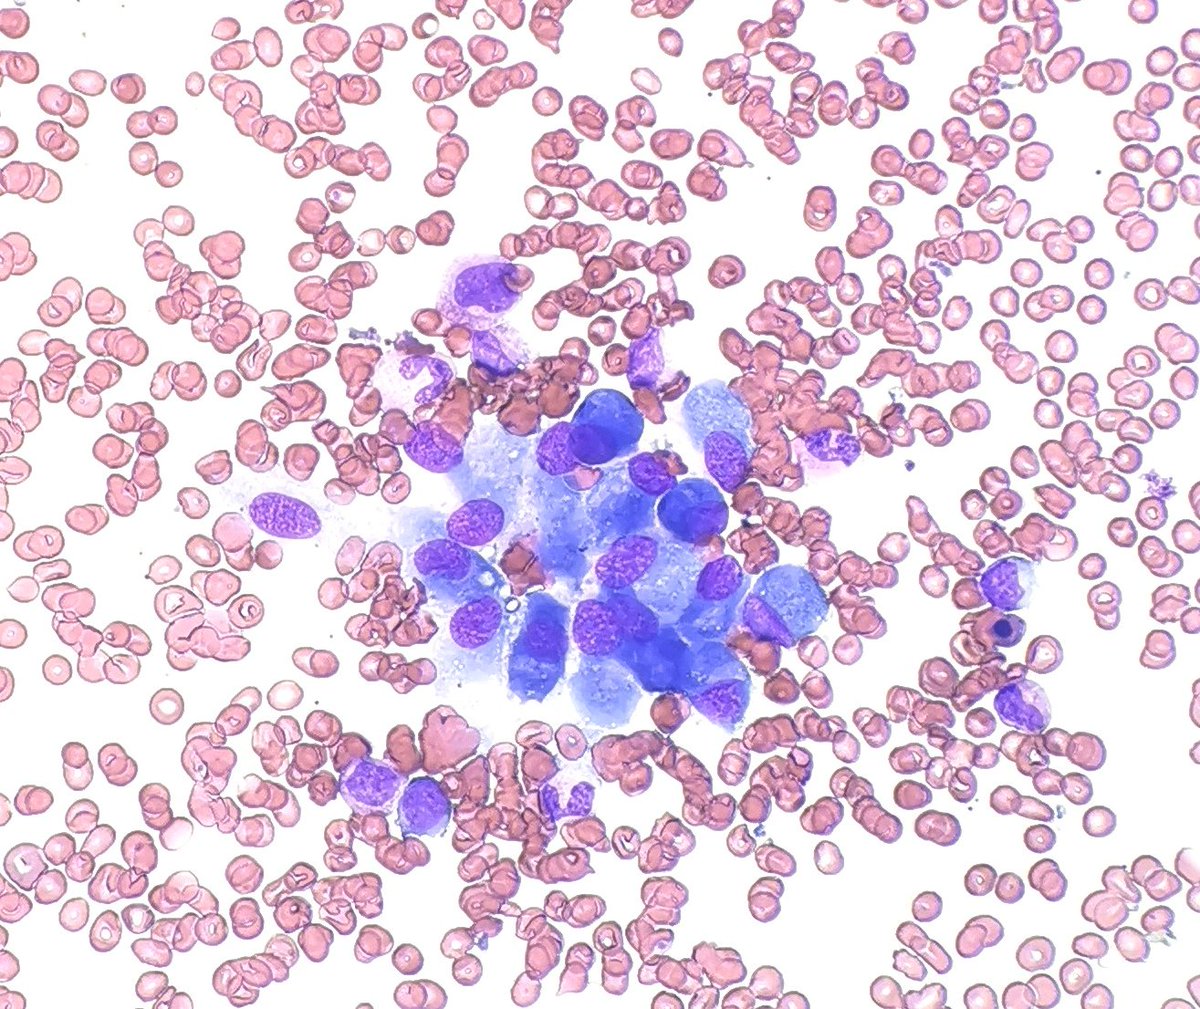
Waht do you want to call these cells on a BM aspirate?

Dr Imteyaz Alam
@imteyazalam
MD pathology
ID: 79732312
04-10-2009 13:40:14
250 Tweet
129 Takipçi
351 Takip Edilen





Woohoo! Free $APE! 🎉 𝕏-Pain 龍為煜 Dharmendra singh alvinlee 🦇🔊 Crypto Channel 329 宮本 正信 Ching_Jebs Mez 🇦🇺 🐉 $MON @meme_coin_5 yurisatori @AeroNimbus lifeisgood.edge🦭🌊RIVER #254643635⛏️ John Ibrahim Cuadra Bitcoin Parody🔸

Got my Apecoin tokens, yay! @yvngmoneymoves MONIKER ⏰🔜 Moniker NFT Marketplace 💥JOIN MM💥 Mike pvmndq55dflu nguyenduongjp TETOSOR @ajtq5643dalrjm MY HOLOGRAM fuz @surensinghkc Blockchain Secrets 29robot Dino Pintzopoulos @kriptobanda xuaohuiliu StepNer Aqilah Arb